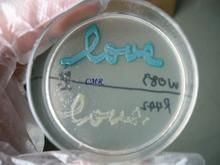
泡囊短波單胞菌

簡介
泡囊短波單胞菌(Brevundimonasvesicularis)是一種較罕見的非發酵性病原性假單胞菌,通常存在於土壤、河流等自然界中,是人類少見的條件致病菌。在人體可引起肺炎、敗血症、皮膚炎症和壞死性蜂窩織炎等。
是一種較罕見的非發酵性病原性假單胞菌。在人體可引起肺炎、敗血症、皮膚炎症和壞死性蜂窩織炎等。
泡囊短波單胞菌(Brevundimonasvesicularis)是一種較罕見的非發酵性病原性假單胞菌,通常存在於土壤、河流等自然界中,是人類少見的條件致病菌。在人體可引起肺炎、敗血症、皮膚炎症和壞死性蜂窩織炎等。
